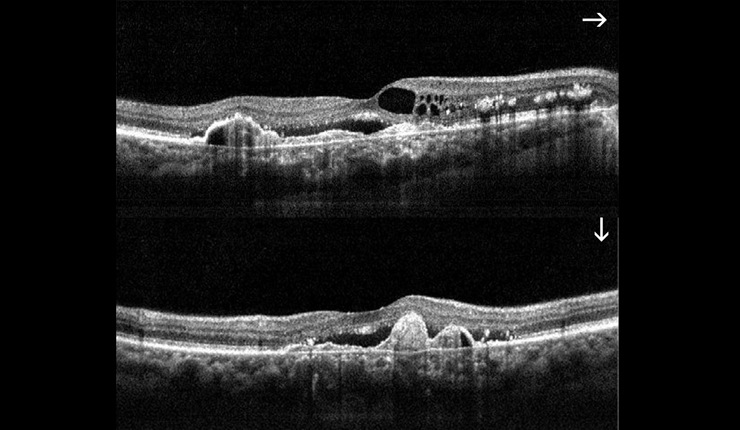

Site Design: www.hartydesign.com
Home | About Ocular Imaging | Contact | Eye Diseases | Prevention | Technology | Links | FAQs
©2010 Ocular Imaging
Ocular Imaging
Highly reflective choroidal neovascular membrane (CNV) associated with AMD. Some residual fluid remaining at the interface of the CNV and outer retina.


Ocular Imaging
Corresponding topographic thickness map of fundus region highlighting shallow fluid temporal to the disc at the left hand side of the image (central blue/green area represents the fovea).


Ocular Imaging
3D OCT of retinal angiomatous proliferation (RAP) showing news vessels tracking through the retina and associated intra-retinal oedema.


Ocular Imaging
AMD. High resolution horizontal and vertical scans showing cystoids oedema, CNV, RPE proliferation and sub retinal fluid at the fovea.

Ocular Imaging
OCT radial scan display showing arcade pattern of fluid associated with branch retinal vein occlusion.


Ocular Imaging
Progression retinal thickness maps showing resolution of fluid following triamcinilone treatment.































